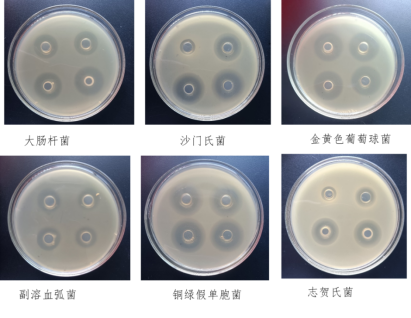
1731718264989.jpg

后生元--復合乳酸菌培養物
后生元--復合乳酸菌培養物專利菌株-抗逆性強-抑菌性強-產酸性強-深層發酵-低溫干燥產品特點抑菌抗腹瀉?:抵抗致病菌感染,降低腹瀉和腸道炎癥的發生?。?增強免疫調節?:具有免疫調節、抗炎、抗過敏等功能,降低疫病發生?。?保護黏膜屏障?:增強
 手機站
手機站 微信咨詢
微信咨詢
后生元--復合乳酸菌培養物
專利菌株-抗逆性強-抑菌性強-產酸性強-深層發酵-低溫干燥
產品特點
抑菌抗腹瀉?:抵抗致病菌感染,降低腹瀉和腸道炎癥的發生?。
?增強免疫調節?:具有免疫調節、抗炎、抗過敏等功能,降低疫病發生?。
?保護黏膜屏障?:增強腸道上皮屏障功能,抵抗外來細菌的侵襲,促進黏膜修復?。
毒素吸附?:其細胞壁肽聚糖、脂磷壁酸和表面蛋白以及胞外多糖等吸附位點得到更多暴露,對霉菌毒素及細菌內毒素的吸附能力增強
促生長?:加快生長速度,改善飼料報酬,降低氨氣排放,改善養殖環境?。

中創后生元作用
1、乳酸菌后生元可有效抑制大腸桿菌、沙門氏菌和金黃色葡萄菌等有害病原菌繁殖
2、評估了乳酸菌后生元對飼料中毒素的吸附作用(Pierides等,2001;Hatab等,2012)
豬生產中的應用
后生元對斷奶仔豬的生產性能有促進作用,使回腸絨毛高度增加了13%,進一步起到促進營養物質吸收的作用。使腸道和糞便中微生物的多樣性顯著增加了18%,糞便中有益菌的相對豐度提高了5%。可以降低育肥豬空腸和結腸凋亡細胞的比例,調節其胃腸道功能。除此之外,后生元還可以改善母豬的繁殖性能。母豬乳汁中乳脂含量增加了23%。
家禽生產中的應用
在家禽養殖過程中,日糧中添加后生元,能夠降低料重比和料蛋比,改善肉品風味,提高肉雞凈膛率,提高產蛋率和雞蛋品質,還能促進免疫器官的發育。此外,后生元的抗氧化或清除氧自由基的活性使其具有保護肝臟的功能。
魚類養殖中的應用
水產動物飼料中添加熱滅活的植物乳桿菌、酵母菌等后生元成分能參與調節魚類腸道免疫反應和菌群平衡,刺激天然免疫系統,維護腸黏膜屏障的完整性,提高免疫機能,還能改善低營養水平帶來的生長緩慢等問題。乳酸等有機酸是后生元的主要活性成分,可使腸道環境呈酸性,抑制病原菌生長達到調節腸道菌群的目的,還能抑制致病菌的繁殖。
反芻動物中的應用
后生元對反芻動物生長性能的影響與動物和后生元種類等有關。滅活的釀酒酵母能夠促進瘤胃微生物的生長并提高其活性;乳酸菌產生的十二碳六烯酸可以改善奶牛瘤胃微生態環境,促進營養物質的消化吸收。除此之外,后生元還能調節反芻動物免疫機能并緩解應激反應。明顯改善奶牛和羔羊的熱應激反應;更重要的是,后生元在治療奶牛乳腺炎、降低乳腺炎發病率等方面也發揮優越作用。
使用方法:
飲水型:100-200克兌水1000千克
拌料型:100-200克拌料1000千克

